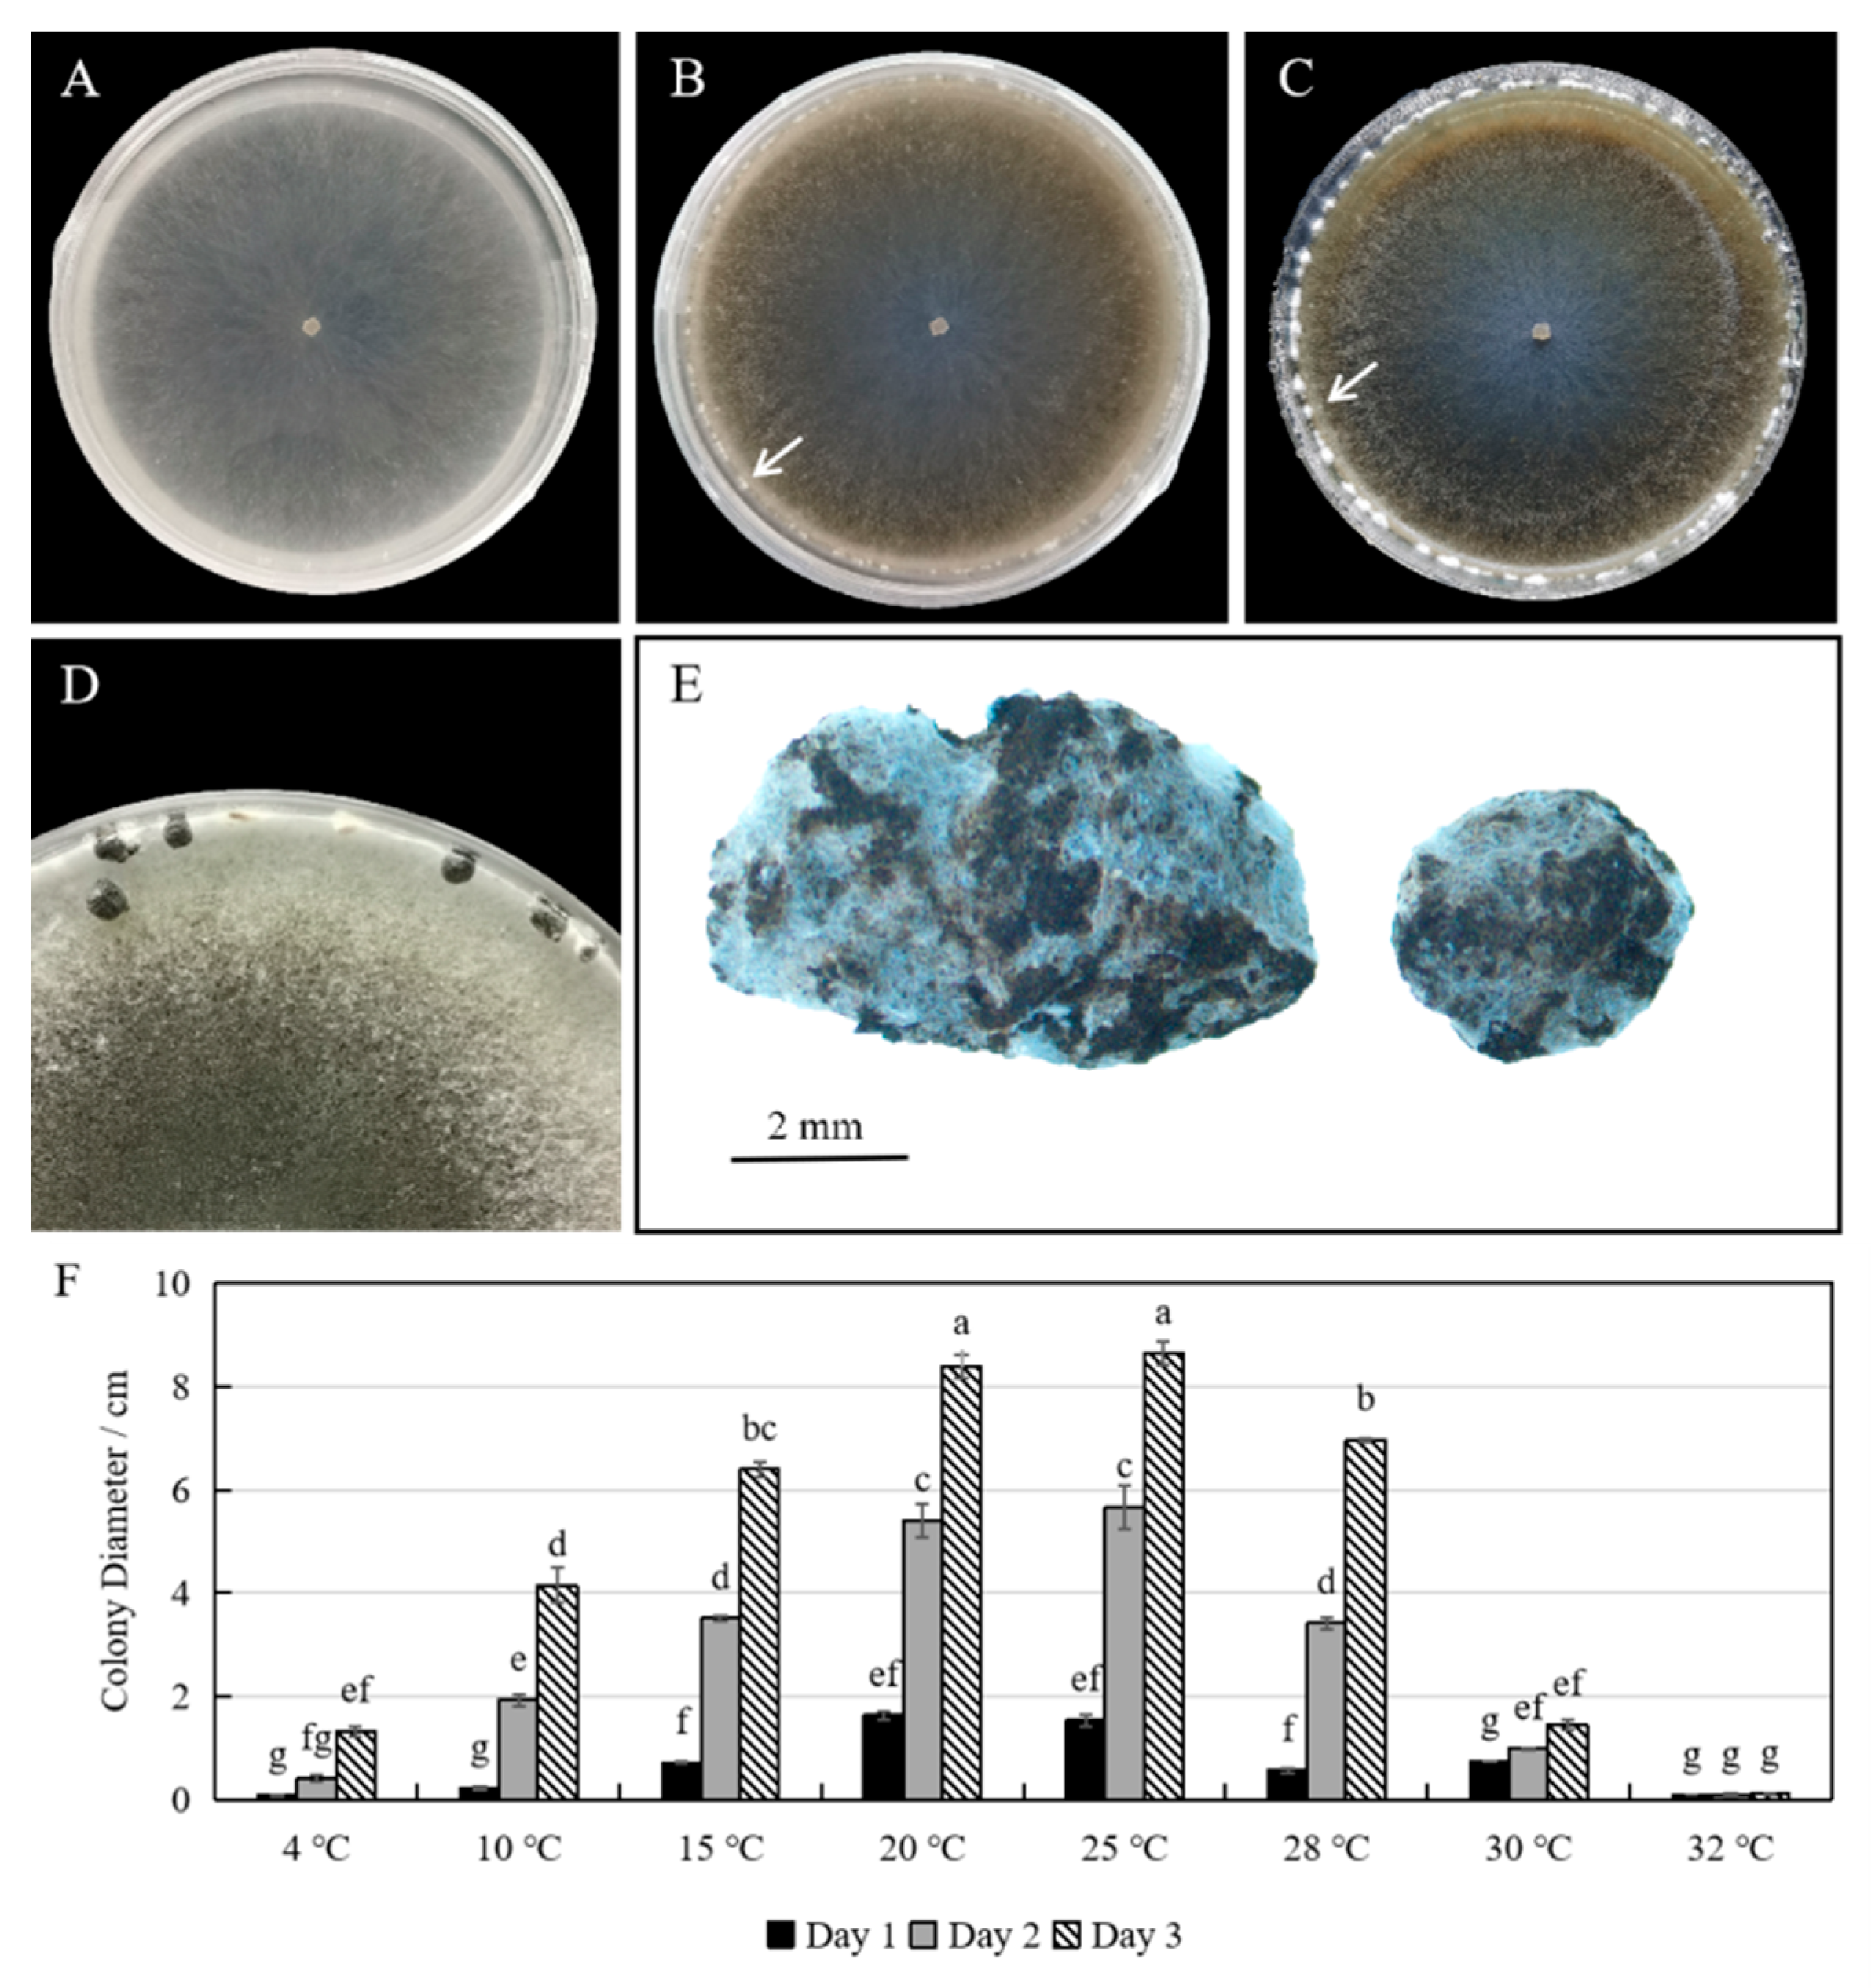
Plants 12 04165 g002 Plants 12 04165 g002

Occurrence and Characterization of Sclerotinia sclerotiorum Causing Fruit Rot on Sweet Cherry in Southern China
Abstract
1. Introduction
2. Results
2.1. Isolation and Identification of Pathogen from Diseased Fruits of Sweet Cherry
2.2. Pathogenicity Tests of S. sclerotiorum on Different Hosts
2.3. Inibitory Effects of Fungicides against S. sclerotiorum
2.4. Control Effects of Fungicides on Sweet Cherry Fruit Rot Caused by S. sclerotiorum
2.5. Genome Assembly and Variation Analysis of S. sclerotiorum Strain ScSs1
3. Discussion
4. Materials and Methods
4.1. Sample Collection and Fungus Isolation
4.2. Morphological and Biological Characterization
4.3. Molecular Identification and Phylogenetic Analysis
4.4. Pathogenicity Tests
4.5. Fungicide Sensitivity Assays
4.6. Fungicide Effects on Controlling Fruit Rot Caused by S. sclerotiorum
4.7. Genomic Analysis
4.7.1. Genomic DNA Library Preparation and Sequencing
4.7.2. Variant Discovery
5. Conclusions
Author Contributions
Funding
Data Availability Statement
Conflicts of Interest
References
- Xanthopoulou, A.; Manioudaki, M.; Bazakos, C.; Kissoudis, C.; Farsakoglou, A.M.; Karagiannis, E.; Michailidis, M.; Polychroniadou, C.; Zambounis, A.; Kazantzis, K.; et al. Whole genome re-sequencing of sweet cherry (Prunus avium L.) yields insights into genomic diversity of a fruit species. Hortic. Res. 2020, 7, 60. [Google Scholar] [CrossRef]
- Pan, L.Y.; Zhou, J.; Sun, Y.; Qiao, B.X.; Wan, T.; Guo, R.Q.; Zhang, J.; Shan, D.Q.; Cai, Y.L. Comparative transcriptome and metabolome analyses of cherry leaves spot disease caused by Alternaria alternata. Front. Plant Sci. 2023, 14, 1129515. [Google Scholar] [CrossRef]
- Wang, J.; Liu, W.; Zhu, D.; Hong, P.; Zhang, S.; Xiao, S.; Tan, Y.; Chen, X.; Xu, L.; Zong, X.; et al. Chromosome-scale genome assembly of sweet cherry (Prunus avium L.) cv. Tieton obtained using long-read and Hi-C sequencing. Hortic. Res. 2020, 7, 122. [Google Scholar] [CrossRef]
- Zhao, Y.; Hou, Z.; Zhang, N.; Ji, H.; Dong, C.; Yu, J.; Chen, X.; Chen, C.; Guo, H. Application of proteomics to determine the mechanism of ozone on sweet cherries (Prunus avium L.) by time-series analysis. Front. Plant Sci. 2023, 14, 1065465. [Google Scholar] [CrossRef]
- Tan, Y.; Wen, B.; Xu, L.; Zong, X.; Sun, Y.; Wei, G.; Wei, H. High temperature inhibited the accumulation of anthocyanin by promoting ABA catabolism in sweet cherry fruits. Front. Plant Sci. 2023, 14, 1079292. [Google Scholar] [CrossRef]
- Zhai, Z.; Xiao, Y.; Wang, Y.; Sun, Y.; Peng, X.; Feng, C.; Zhang, X.; Du, B.; Zhou, X.; Wang, C.; et al. Abscisic acid-responsive transcription factors PavDof2/6/15 mediate fruit softening in sweet cherry. Plant Physiol. 2022, 190, 2501–2518. [Google Scholar] [CrossRef]
- Chen, C.; Chen, H.; Yang, W.; Li, J.; Tang, W.; Gong, R. Transcriptomic and Metabolomic Analysis of Quality Changes during Sweet Cherry Fruit Development and Mining of Related Genes. Int. J. Mol. Sci. 2022, 23, 7402. [Google Scholar] [CrossRef]
- Silveira Rabelo, A.C.; Mertens-Talcott, S.U.; Chew, B.P.; Noratto, G. Dark Sweet Cherry (Prunus avium) Anthocyanins Suppressed ERK1/2-Akt/mTOR Cell Signaling and Oxidative Stress: Implications for TNBC Growth and Invasion. Molecules 2022, 27, 7245. [Google Scholar] [CrossRef]
- Chu, L.; Zheng, W.; Wang, J.; Wang, Z.; Zhao, W.; Zhao, B.; Xu, G.; Xiao, M.; Lou, X.; Pan, F.; et al. Comparative analysis of the difference in flavonoid metabolic pathway during coloring between red-yellow and red sweet cherry (Prunus avium L.). Gene 2023, 880, 147602. [Google Scholar] [CrossRef]
- Antognoni, F.; Potente, G.; Mandrioli, R.; Angeloni, C.; Freschi, M.; Malaguti, M.; Hrelia, S.; Lugli, S.; Gennari, F.; Muzzi, E.; et al. Fruit Quality Characterization of New Sweet Cherry Cultivars as a Good Source of Bioactive Phenolic Compounds with Antioxidant and Neuroprotective Potential. Antioxidants 2020, 9, 677. [Google Scholar] [CrossRef]
- Wang, L.; Zhang, L.; Ma, C.; Xu, W.; Liu, Z.; Zhang, C.; Whiting, D.; Wang, S. Impact of chilling accumulation and hydrogen cyanamide on floral organ development of sweet cherry in a warm region. J. Integr. Agric. 2016, 15, 2529–2538. [Google Scholar] [CrossRef]
- Wang, J.; Gao, Z.; Li, H.; Jiu, S.; Qu, Y.; Wang, L.; Ma, C.; Xu, W.; Wang, S.; Zhang, C. Dormancy-Associated MADS-Box (DAM) Genes Influence Chilling Requirement of Sweet Cherries and Co-Regulate Flower Development with SOC1 Gene. Int. J. Mol. Sci. 2020, 21, 921. [Google Scholar] [CrossRef]
- Wang, J.; Liu, X.; Sun, W.; Xu, Y.; Sabir, I.A.; Abdullah, M.; Wang, S.; Jiu, S.; Zhang, C. Cold induced genes (CIGs) regulate flower development and dormancy in Prunus avium L. Plant Sci. 2021, 313, 111061. [Google Scholar] [CrossRef]
- Serdani, M.; Spotts, R.A. First Report of Blossom Blight and Green Fruit Rot of Sweet Cherry Caused by Sclerotinia sclerotiorum in Oregon. Plant Dis. 2007, 91, 1058. [Google Scholar] [CrossRef]
- Tang, Z.; Lou, J.; He, L.; Wang, Q.; Chen, L.; Zhong, X.; Wu, C.; Zhang, L.; Wang, Z. First report of Colletotrichum fructicola causing anthracnose on cherry (Prunus avium) in China. Plant Dis. 2021, 16, 317. [Google Scholar] [CrossRef]
- Peng, K.; Pan, Y.; Tan, T.; Zeng, X.; Lin, M.; Jiang, S.; Zhao, Z.; Tian, F.; Zhao, X. Characterization and fungicide sensitivity of Colletotrichum godetiae causing sweet cherry fruit anthracnose in Guizhou, China. Front. Microbiol. 2022, 13, 923181. [Google Scholar] [CrossRef]
- Jiu, S.; Chen, B.; Dong, X.; Lv, Z.; Wang, Y.; Yin, C.; Xu, Y.; Zhang, S.; Zhu, J.; Wang, J.; et al. Chromosome-scale genome assembly of Prunus pusilliflora provides novel insights into genome evolution, disease resistance, and dormancy release in Cerasus L. Hortic. Res. 2023, 10, uhad062. [Google Scholar] [CrossRef]
- Beltrán, F.; Correa, F.; Moreno, Z.; Otarola, J.; Sagredo, B.; Millas, P. First report of Pseudomonas viridiflava causing fruit rot on sweet cherry trees in Chile. Plant Dis. 2022, 27, 1216. [Google Scholar] [CrossRef]
- Zhou, Y.; Zhang, W.; Li, X.; Ji, S.; Chethana, K.W.T.; Hyde, K.D.; Yan, J. Fusarium Species Associated with Cherry Leaf Spot in China. Plants 2022, 11, 2760. [Google Scholar] [CrossRef]
- Zhou, Y.; Zhang, W.; Li, Y.; Ji, S.; Li, X.; Hyde, K.D.; Zhang, K.; Phillips, A.J.L.; Manawasinghe, I.S.; Yan, J. Identification and Characterization of Colletotrichum Species Associated with Cherry Leaf Spot Disease in China. Plant Dis. 2023, 107, 500–513. [Google Scholar] [CrossRef]
- Adaskaveg, J.E.; Förster, H.; Thompson, D.F. Identification and Etiology of Visible Quiescent Infections of Monilinia fructicola and Botrytis cinerea in Sweet Cherry Fruit. Plant Dis. 2000, 84, 328–333. [Google Scholar] [CrossRef] [PubMed][Green Version]
- Ferrada, E.E.; Díaz, G.A.; Zoffoli, J.P.; Latorre, B.A. First Report of Blossom Blight Caused by Sclerotinia sclerotiorum on Japanese Plum, Nectarine, and Sweet Cherry Orchards in Chile. Plant Dis. 2014, 98, 695. [Google Scholar] [CrossRef] [PubMed]
- Chen, F.; Liu, X.; Schnabel, G. First Report of Brown Rot Caused by Monilinia fructicola in Sweet Cherry in Maryland. Plant Dis. 2013, 97, 145. [Google Scholar] [CrossRef] [PubMed]
- Cancino, S.; Lolas, M.A.; Galdós, L.; Hernández, Y.; Ferrada, E.; Riveros, P.; Blanco-Ulate, B.; Díaz, G.A. Occurrence of Alternaria alternata and A. tenuissima causing black rot in cherry fruits (Prunus avium) in Central Chile. Plant Dis. 2023, 13, DIS-07. [Google Scholar] [CrossRef] [PubMed]
- Yin, W.X.; Adnan, M.; Shang, Y.; Lin, Y.; Luo, C.X. Sensitivity of Botrytis cinerea from Nectarine/Cherry in China to Six Fungicides and Characterization of Resistant Isolates. Plant Dis. 2018, 102, 2578–2585. [Google Scholar] [CrossRef]
- Xi, L.Q.; Zhang, S.K.; Chen, Y.S.; Zhou, Y.N.; Zhang, Q.Y.; Xin, L.; Zhang, Q.; Wu, P. Isolation of ‘Mei Zao’ Sweet Cherry Brown Rot Pathogens and Identification of Endogenous Antagonistic Bacteria. Food Ferment. Ind. 2020, 46, 85–91. [Google Scholar]
- Derbyshire, M.C.; Newman, T.E.; Khentry, Y.; Owolabi Taiwo, A. The evolutionary and molecular features of the broad-host-range plant pathogen Sclerotinia sclerotiorum. Mol. Plant Pathol. 2022, 23, 1075–1090. [Google Scholar] [CrossRef]
- Ibrahim, H.M.M.; Kusch, S.; Didelon, M.; Raffaele, S. Genome-wide alternative splicing profiling in the fungal plant pathogen Sclerotinia sclerotiorum during the colonization of diverse host families. Mol. Plant Pathol. 2021, 22, 31–47. [Google Scholar] [CrossRef]
- Derbyshire, M.; Denton-Giles, M.; Hegedus, D.; Seifbarghy, S.; Rollins, J.; van Kan, J.; Seidl, M.F.; Faino, L.; Mbengue, M.; Navaud, O.; et al. The complete genome sequence of the phytopathogenic fungus Sclerotinia sclerotiorum reveals insights into the genome architecture of broad host range pathogens. Genome Biol. Evol. 2017, 9, 593–618. [Google Scholar] [CrossRef]
- Hossain, M.M.; Sultana, F.; Li, W.; Tran, L.P.; Mostofa, M.G. Sclerotinia sclerotiorum (Lib.) de Bary: Insights into the Pathogenomic Features of a Global Pathogen. Cells 2023, 12, 1063. [Google Scholar] [CrossRef]
- Wang, Z.; Ma, L.Y.; Cao, J.; Li, Y.L.; Ding, L.N.; Zhu, K.M.; Yang, Y.H.; Tan, X.L. Recent Advances in Mechanisms of Plant Defense to Sclerotinia sclerotiorum. Front. Plant Sci. 2019, 10, 1314. [Google Scholar] [CrossRef]
- Hou, Y.P.; Mao, X.W.; Wu, L.Y.; Wang, J.X.; Mi, B.; Zhou, M.G. Impact of fluazinam on morphological and physiological characteristics of Sclerotinia sclerotiorum. Pestic. Biochem. Physiol. 2019, 155, 81–89. [Google Scholar] [CrossRef]
- Lin, L.; Li, X.; Liao, Y.; Lu, Q.; Yuan, G.; Lin, W. First Report of Sclerotinia sclerotiorum Causing Hibiscus rosa-sinensis Stem Rot in Guangxi, China. Plant Dis. 2023, 5, DIS-017. [Google Scholar] [CrossRef]
- Lee, J.H.; Kwon, Y.H.; Kwack, Y.B.; Kwak, Y.S. Report of postharvest rot of kiwifruit in Korea caused by Sclerotinia sclerotiorum. Int. J. Food Microbiol. 2015, 206, 81–83. [Google Scholar] [CrossRef]
- Hellman, E.M.; Koivunen, E.E.; Swett, C.L. First Report of Sclerotinia Fruit and Crown Rot Caused by Sclerotinia sclerotiorum on Short-Day Strawberry in Maryland. Plant Dis. 2022, 106, 764. [Google Scholar] [CrossRef] [PubMed]
- Marin, M.V.; Peres, N.A. First Report of Sclerotinia sclerotiorum Causing Strawberry Fruit Rot in Florida. Plant Dis. 2020, 104, 3250. [Google Scholar] [CrossRef] [PubMed]
- Ayvar-Serna, S.; Díaz-Nájera, J.F.; Tejeda-Reyes, M.A.; Mora-Romero, G.A.; Pérez-Mora, J.L.; Tovar-Pedraza, J.M. First Report of White Mold Caused by Sclerotinia sclerotiorum on Brussels Sprouts in Mexico. Plant Dis. 2023, 107, 3300. [Google Scholar] [CrossRef] [PubMed]
- Kim, J.Y.; Aktaruzzaman, M.; Afroz, T.; Hahm, Y.I.; Kim, B.S. The First Report of Postharvest Stem Rot of Kohlrabi Caused by Sclerotinia sclerotiorum in Korea. Mycobiology 2014, 42, 409–411. [Google Scholar] [CrossRef]
- Yang, X.; Justice, A.; Colburn, C. First report of Sclerotinia sclerotiorum causing stem canker on industrial hemp in South Carolina, USA. Plant Dis. 2023, 107, 2870. [Google Scholar] [CrossRef]
- Zhang, X.; Xian, W.; Qu, M.; Xu, M.; Guo, Z.; Yu, J.; He, K.; Yang, M.; Chi, Y. First Report of Sclerotinia Blight on Peanut Caused by Sclerotinia sclerotiorum in Qinghai Province, China. Plant Dis. 2022, 106, 1301. [Google Scholar] [CrossRef]
- Islam, M.R.; Akanda, A.M.; Hossain, M.M. First characterization of a newly emerging phytopathogen, Sclerotinia sclerotiorum causing white mold in pea. J. Basic Microbiol. 2021, 61, 923–939. [Google Scholar] [CrossRef] [PubMed]
- Freeman, J.; Ward, E.; Calderon, C.; McCartney, A. A Polymerase Chain Reaction (PCR) Assay for the Detection of Inoculum of Sclerotinia sclerotiorum. Eur. J. Plant Pathol. 2002, 108, 877–886. [Google Scholar] [CrossRef]
- Jiu, S.T.; Xu, Y.; Liao, Z.H.; Wang, L.; Wang, J.Y.; Liu, X.J.; Wang, S.P.; Zhang, C.X. Evaluation and Research of the Biological Characteristics of Sweet Cherries in Shanghai. Mol. Plant Breed. 2021, 19, 4164–4176. [Google Scholar]
- Zhang, C.; Liu, H.; Xi, D.J.; Pei, J.B.; Huang, K.K.; Luo, H.F.; Shen, G.Z. Comparative study on flower bud inclusion and quality in different development stages of sweet cherry from Hangzhou and Tai’an. J. Fruit. Sci. 2021, 38, 1308–1318. [Google Scholar]
- Jin, W.; Wang, H.; Li, M.; Wang, J.; Yang, Y.; Zhang, X.; Yan, G.; Zhang, H.; Liu, J.; Zhang, K. The R2R3 MYB transcription factor PavMYB10.1 involves in anthocyanin biosynthesis and determines fruit skin colour in sweet cherry (Prunus avium L.). Plant Biotechnol. J. 2016, 14, 2120–2133. [Google Scholar] [CrossRef] [PubMed]
- Duan, Y.; Yang, Y.; Wang, Y.; Pan, X.; Wu, J.; Cai, Y.; Li, T.; Zhao, D.; Wang, J.; Zhou, M. Loop-Mediated Isothermal Amplification for the Rapid Detection of the F200Y Mutant Genotype of Carbendazim-Resistant Isolates of Sclerotinia sclerotiorum. Plant Dis. 2016, 100, 976–983. [Google Scholar] [CrossRef] [PubMed]
- Li, Y.H.; Zhou, B.L.; Qian, M.R.; Wang, Q.; Zhang, H. Transfer Assessment of Carbendazim Residues from Rape Flowers to Apicultural Products. J. Anal. Methods Chem. 2017, 2017, 6075405. [Google Scholar] [CrossRef]
- Sharma, M.; Maheshwari, N.; Khan, F.H.; Mahmood, R. Carbendazim toxicity in different cell lines and mammalian tissues. J. Biochem. Mol. Toxicol. 2022, 36, e23194. [Google Scholar] [CrossRef]
- Zhou, T.; Guo, T.; Wang, Y.; Wang, A.; Zhang, M. Carbendazim: Ecological risks, toxicities, degradation pathways and potential risks to human health. Chemosphere 2023, 314, 137723. [Google Scholar] [CrossRef]
- Yao, S.; Zhao, Z.; Lu, W.; Dong, X.; Hu, J.; Liu, X. Evaluation of Dissipation Behavior, Residues, and Dietary Risk Assessment of Fludioxonil in Cherry via QuEChERS Using HPLC-MS/MS Technique. Molecules 2021, 26, 3344. [Google Scholar] [CrossRef]
- Kuivila, K.M.; Judd, H.; Hladik, M.L.; Strange, J.P. Field-Level Exposure of Bumble Bees to Fungicides Applied to a Commercial Cherry Orchard. J. Econ. Entomol. 2021, 114, 1065–1071. [Google Scholar] [CrossRef]
- Zhao, E.; Xie, A.; Wang, D.; Du, X.; Liu, B.; Chen, L.; He, M.; Yu, P.; Jing, J. Residue behavior and risk assessment of pyraclostrobin and tebuconazole in peppers under different growing conditions. Environ. Sci. Pollut. Res. Int. 2022, 29, 84096–84105. [Google Scholar] [CrossRef] [PubMed]
- Amselem, J.; Cuomo, C.A.; van Kan, J.A.; Viaud, M.; Benito, E.P.; Couloux, A.; Coutinho, P.M.; de Vries, R.P.; Dyer, P.S.; Fillinger, S.; et al. Genomic analysis of the necrotrophic fungal pathogens Sclerotinia sclerotiorum and Botrytis cinerea. PLoS Genet. 2011, 7, e1002230. [Google Scholar] [CrossRef]
- Zhang, X.; Cheng, X.; Liu, L.; Liu, S. Genome Sequence Resource for the Plant Pathogen Sclerotinia sclerotiorum WH6 Isolated in China. Plant Dis. 2021, 105, 3720–3722. [Google Scholar] [CrossRef] [PubMed]
- Czarnecka, D.; Skomra, U.; Korbecka-Glinka, G. First report of Sclerotinia sclerotiorum causing Sclerotinia wilt of hop (Humulus lupulus) in Poland. Plant Dis. 2023, 107, 3636. [Google Scholar] [CrossRef] [PubMed]
- Zhao, W.; Hu, A.; Ren, M.; Wei, G.; Xu, H. First Report on Colletotrichum fructicola Causing Anthracnose in Chinese Sorghum and Its Management Using Phytochemicals. J. Fungi 2023, 9, 279. [Google Scholar] [CrossRef]
- Ruan, R.; Xi, D.; Zhang, C.; Huang, K.; Luo, H.; Liu, H. Alternaria alternata causing brown spot on kiwiberry (Actinidia arguta) in China. Crop Prot. 2021, 152, 105857. [Google Scholar] [CrossRef]
- Guindon, S.; Dufayard, J.F.; Lefort, V.; Anisimova, M.; Hordijk, W.; Gascuel, O. New algorithms and methods to estimate maximum-likelihood phylogenies: Assessing the performance of PhyML 3.0. Syst. Biol. 2010, 59, 307–321. [Google Scholar] [CrossRef]
- Ruan, R.; Chung, K.R.; Li, H. Functional characterization of the Dsc E3 ligase complex in the citrus postharvest pathogen Penicillium digitatum. Microbiol. Res. 2017, 205, 99–106. [Google Scholar] [CrossRef]
- Li, W.; Long, Y.; Mo, F.; Shu, R.; Yin, X.; Wu, X.; Zhang, R.; Zhang, Z.; He, L.; Chen, T.; et al. Antifungal Activity and Biocontrol Mechanism of Fusicolla violacea J-1 against Soft Rot in Kiwifruit Caused by Alternaria alternata. J. Fungi 2021, 7, 937. [Google Scholar] [CrossRef]
- Chen, S.; Zhou, Y.; Chen, Y.; Gu, J. fastp: An ultra-fast all-in-one FASTQ preprocessor. Bioinformatics 2018, 34, i884–i890. [Google Scholar] [CrossRef]
- Jung, Y.; Han, D. BWA-MEME: BWA-MEM emulated with a machine learning approach. Bioinformatics 2022, 38, 2404–2413. [Google Scholar] [CrossRef]
- McKenna, A.; Hanna, M.; Banks, E.; Sivachenko, A.; Cibulskis, K.; Kernytsky, A.; Garimella, K.; Altshuler, D.; Gabriel, S.; Daly, M.; et al. The Genome Analysis Toolkit: A MapReduce framework for analyzing next-generation DNA sequencing data. Genome Res. 2010, 20, 1297–1303. [Google Scholar] [CrossRef] [PubMed]
- Li, H.; Handsaker, B.; Wysoker, A.; Fennell, T.; Ruan, J.; Homer, N.; Marth, G.; Abecasis, G.; Durbin, R. The Sequence Alignment/Map format and SAMtools. Bioinformatics 2009, 25, 2078–2079. [Google Scholar] [CrossRef] [PubMed]
- Freed, D.; Aldana, R.; Weber, J.A.; Edwards, J.S. The Sentieon Genomics Tools—A Fast and Accurate Solution to Variant Calling from Next-Generation Sequence Data; Cold Spring Harbor Laboratory: Cold Spring Harbor, NY, USA, 2017. [Google Scholar]
- Chen, X.; Schulz-Trieglaff, O.; Shaw, R.; Barnes, B.; Schlesinger, F.; Källberg, M.; Cox, A.J.; Kruglyak, S.; Saunders, C.T. Manta: Rapid detection of structural variants and indels for germline and cancer sequencing applications. Bioinformatics 2016, 32, 1220–1222. [Google Scholar] [CrossRef] [PubMed]
- Talevich, E.; Shain, A.H.; Botton, T.; Bastian, B.C. CNVkit: Genome-Wide Copy Number Detection and Visualization from Targeted DNA Sequencing. PLoS Comput. Biol. 2016, 12, e1004873. [Google Scholar] [CrossRef]
- Cingolani, P.; Platts, A.; Wang, L.L.; Coon, M.; Nguyen, T.; Wang, L.; Land, S.J.; Lu, X.; Ruden, D.M. A program for annotating and predicting the effects of single nucleotide polymorphisms, SnpEff: SNPs in the genome of Drosophila melanogaster strain w1118; iso-2; iso-3. Fly 2012, 6, 80–92. [Google Scholar] [CrossRef]

| Species | Strain Accession | Origin | GenBank Accession of ITS |
|---|---|---|---|
| Sclerotinia sclerotiorum | CBS 499.50 | Netherlands | MH856725 |
| Sclerotinia sclerotiorum | ATCC MYA-4521 | USA | FJ810516 |
| Sclerotinia sclerotiorum | ATCC 46762 | USA | JX648201 |
| Sclerotinia trifoliorum | CBS 171.24 | USA | MF964318 |
| Sclerotinia trifoliorum | CBS 122377 | Poland | KT970794 |
| Sclerotinia nivalis | KACC 45150 | Korea | HM746662 |
| Sclerotinia nivalis | KACC 45151 | Korea | HM746663 |
| Sclerotinia asari | CBS 139.91 | USA | MF964313 |
| Sclerotinia spermophila | CBS 219.46 | USA | MF964316 |
| Sclerotinia sulcata | CBS 303.31 | Netherlands | MH855222 |
| Sclerotinia pseudotuberosa | CBS 327.75 | Italy | AY526234 |
| Sclerotinia pseudotuberosa | CBS 655.78 | Italy | AY526231 |
| Sclerotinia minor | CBS 207.25 | Netherlands | MH854848 |
| Sclerotinia bulborum | CBS 297.31 | Netherlands | MH855218 |
| Sclerotinia sativa | CBS 339.47 | Netherlands | MH856278 |
| Colletotrichum gloeosporioides | CBS 95397 | Thailand | FJ972609 |
| Fungicides | Regression Equation | EC50 (μg/mL) | Coefficient of Determination (R2) | 95% Confidence Interval |
|---|---|---|---|---|
| Difenoconazole | y = 0.76 + 1.79x | 0.38 ± 0.00 | 0.847 | 0.21~0.55 |
| Pyraclostrobin | y = 0.84 + 0.92x | 0.16 ± 0.03 | 0.891 | 0.00~0.43 |
| Carbendazim | y = 1.75 + 1.89x | 0.15 ± 0.00 | 0.942 | 0.10~0.24 |
| Azoxystrobin | y = −1.12 + 1.54x | 5.62 ± 0.07 | 0.954 | 3.34~7.74 |
| Procymidone | y = 1.32 + 2.87x | 0.36 ± 0.00 | 0.890 | 0.25~0.47 |
| Chlorothalonil | y = 0.64 + 0.96x | 0.32 ± 0.00 | 0.874 | 0.00~0.96 |
| Boscalid | y = 0.76 + 1.79x | 0.56 ± 0.05 | 0.915 | 0.05~1.43 |
| Fludioxonil | y = 3.06 + 1.71x | 0.02 ± 0.00 | 0.885 | 0.01~0.03 |
| Tebuconazole | y = 0.64 + 1.73x | 0.44 ± 0.02 | 0.952 | 0.08~0.77 |
| Propiconazole | y = 0.84 + 1.88x | 0.37 ± 0.01 | 0.935 | 0.25~0.51 |
| Host Cultivars | Fludioxonil | Carbendazim | Pyraclostrobin | |||
|---|---|---|---|---|---|---|
| 0.1 μg/mL | 1 μg/mL | 0.1 μg/mL | 1 μg/mL | 0.1 μg/mL | 1 μg/mL | |
| Summit | 9.03 ± 1.70 a | 76.13 ± 1.25 d | 57.63 ± 6.89 c | 23.01 ± 5.73 ab | 17.42 ± 1.87 ab | 88.39 ± 2.99 de |
| Brooks | 50.83 ± 9.49 c | 96.68 ± 2.17 e | 17.32 ± 0.72 ab | 33.66 ± 4.42 b | 37.25 ± 5.17 b | 98.04 ± 1.88 e |
| Zaodaguo | -- | 97.22 ± 2.62 e | -- | 58.33 ± 4.90 c | -- | 100.00 ± 0.00 e |
| Lapins | -- | 11.03 ± 7.26 a | -- | 5.67 ± 5.46 a | -- | 6.90 ± 6.60 a |
| Hongmi | -- | 39.25 ± 10.00 b | -- | 7.88 ± 7.84 a | -- | 47.81 ± 11.23 c |
Disclaimer/Publisher’s Note: The statements, opinions and data contained in all publications are solely those of the individual author(s) and contributor(s) and not of MDPI and/or the editor(s). MDPI and/or the editor(s) disclaim responsibility for any injury to people or property resulting from any ideas, methods, instructions or products referred to in the content. |
© 2023 by the authors. Licensee MDPI, Basel, Switzerland. This article is an open access article distributed under the terms and conditions of the Creative Commons Attribution (CC BY) license (https://creativecommons.org/licenses/by/4.0/).
Share and Cite
Ruan, R.; Huang, K.; Luo, H.; Zhang, C.; Xi, D.; Pei, J.; Liu, H. Occurrence and Characterization of Sclerotinia sclerotiorum Causing Fruit Rot on Sweet Cherry in Southern China. Plants 2023, 12, 4165. https://doi.org/10.3390/plants12244165
Ruan R, Huang K, Luo H, Zhang C, Xi D, Pei J, Liu H. Occurrence and Characterization of Sclerotinia sclerotiorum Causing Fruit Rot on Sweet Cherry in Southern China. Plants. 2023; 12(24):4165. https://doi.org/10.3390/plants12244165
Chicago/Turabian StyleRuan, Ruoxin, Kangkang Huang, Huifeng Luo, Chen Zhang, Dujun Xi, Jiabo Pei, and Hui Liu. 2023. "Occurrence and Characterization of Sclerotinia sclerotiorum Causing Fruit Rot on Sweet Cherry in Southern China" Plants 12, no. 24: 4165. https://doi.org/10.3390/plants12244165
APA StyleRuan, R., Huang, K., Luo, H., Zhang, C., Xi, D., Pei, J., & Liu, H. (2023). Occurrence and Characterization of Sclerotinia sclerotiorum Causing Fruit Rot on Sweet Cherry in Southern China. Plants, 12(24), 4165. https://doi.org/10.3390/plants12244165





